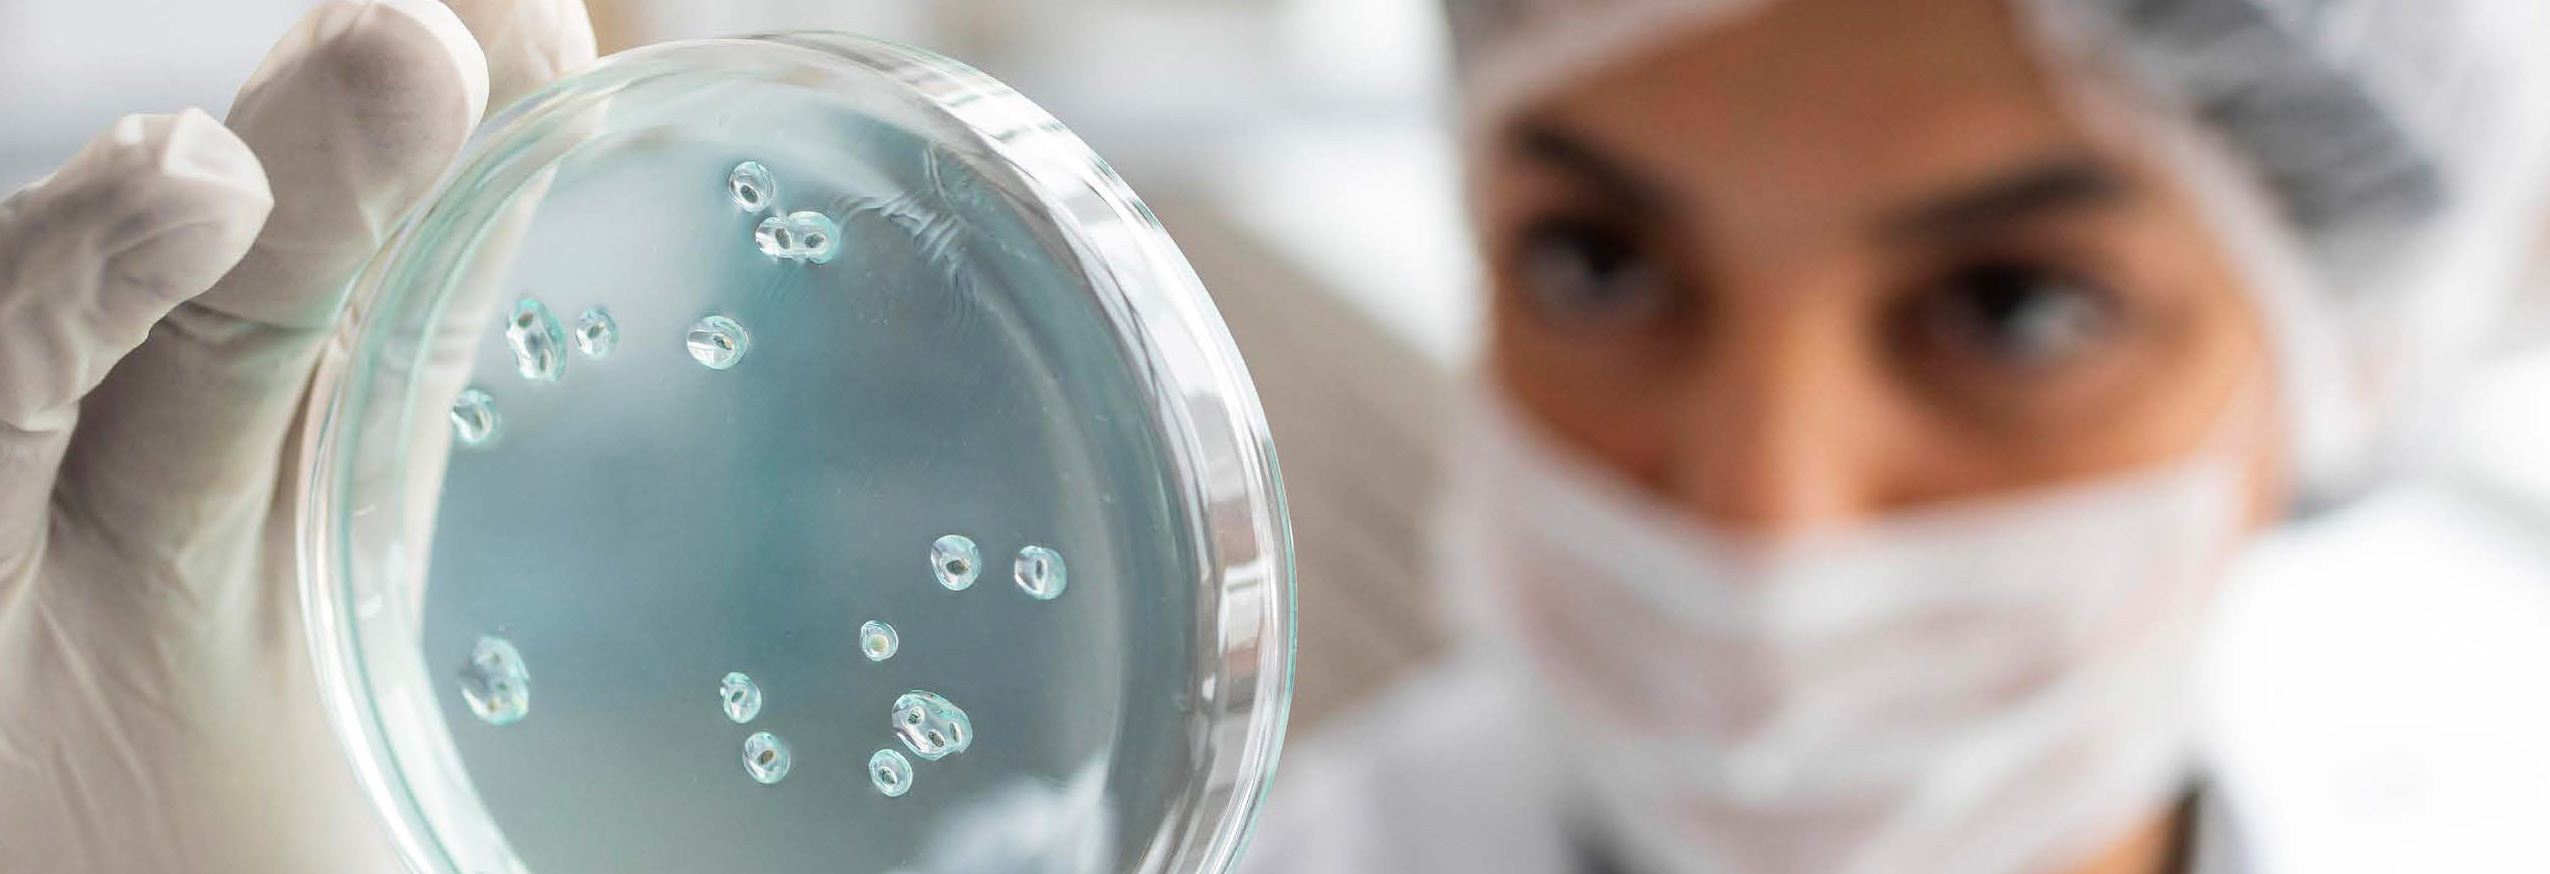
A pathologist looking at petri dish

BOOK REVIEW
Conflict Resilience: Negotiating Disagreement Without Giving Up or Giving In
![]()
Robert C. Bordone, Joel Salinas, MD, Harper Business; March 2025
Reviewed by Ruth Vilayil, MD
 In medicine, we’re trained to diagnose and treat disease, but rarely are we taught how to navigate workplace conflict. For many of us, it feels like going into a Code Blue without any ACLS algorithm cards.
In medicine, we’re trained to diagnose and treat disease, but rarely are we taught how to navigate workplace conflict. For many of us, it feels like going into a Code Blue without any ACLS algorithm cards.
Conflict Resilience is written by a Harvard Law professor and a neurologist. Using stories and neuroscience, they unpack the modern need for the title concept, which they define as “the ability to genuinely sit with and grow from conflict.” They describe a structured approach to preparing for and facing conflict, not shying away from mundane and even controversial example topics, and including brain science along the way. According to their framework: NAME the conflict, EXPLORE fully the issues involved, COMMIT to doing your part in facing the conflict.
Bordone and Salinas’s intended audience is any lay person or professional who finds conflict difficult to navigate. It is an excellent book for any physician leader, as the complexity of health care creates ripe ground for potential conflict. Although several excellent books on this topic already exist, this one is entirely different in its focus on building a comprehensive approach from the inside out, underpinned by the neuroscience that explains what works and what doesn’t. In addition, the authors use contemporary and relatable examples. Rather than discussing geopolitical scenarios or simple price bargaining, they give examples of a health care workplace disagreement or differing political opinions among family members at Thanksgiving.
These are my top three leadership lessons learned from Conflict Resilience.
The concept of conflict tolerance
This involves both conflict recognition (our internal tendency for labeling an event as “conflict”) and conflict holding (our ability to sit with conflict). This varies for different people. Understanding this improves our self-awareness as a leader and increases empathy for those on our teams who are having a different experience of conflict than we are.
Three steps to better conflict negotiation as a leader:
- Mirror work: self-examination and brutal honesty with ourselves around our true interests and motivations in the conflict.
- Chair work: practising conversations with different sides of ourselves
on the topic at hand. - Table work: bravely bringing the conflict to the table with our counterparts, truly understanding their side while also communicating our point of view, resisting the urge to run away. I conceptualize this as the ability to “listen up, speak up.”
Information and examples on leading cultural change (whether you are in charge and have a title or not)
Individual up-skilling is not enough; the entire culture around the organization’s approach to conflict must shift as well. There are valuable pearls of wisdom here from those who have pioneered seismic changes.
This book is packed with stories, research, and practical tools. For physician leaders in particular, this book gives wisdom not only for our own up-skilling in the area of conflict negotiation, but also insight into how those we lead may be experiencing it too. That empathy can move conflicts forward monumentally. As a physician, Salinas’s stories and insights are completely relatable.
Unfortunately, because of the book’s comprehensiveness, readers can lose track of which section or skill they’re currently focusing on. Diagrams would have been a nice addition to keep the reader oriented. However, it remains a practical, innovative guide that can help us translate book-knowledge into action in our personal lives and organizations.
While navigating conflict may never be algorithmic like a Code Blue, the frameworks in this book are a great way to confidently approach — even embrace — any conflict that comes your way.
Author
Dr. Ruth Vilayil, a specialist in obstetrics and gynecology and a fellow of the Royal College of Surgeons of Canada, led a renowned international women’s hospital in Uganda. Now regional division head — gynecology for Fraser Health Authority and clinical assistant professor at UBC, she holds certificates in physician quality improvement and leadership.
Correspondence to:
ruth.vilayil@gmail.com